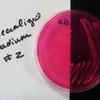

| ||||
Test Your Knowledge of Specialized Bacterial Growth Media
Science Image Library
Specialized Growth Media Streaked with
Unknown Bacteria for Testing Students
from Science Prof Online
1. What can you conclude if a plate of MAS is streaked with unknown and then shows no bacterial growth?; 2. Two Mannitol Salt plates streaked with different unknowns; 3 & 4. Two Mannitol Salt plates streaked with different unknowns; 5. Mannitolo salt plate on left, MacConkeys on right (with no growth on MAC);
Mannitol Salt Streaked with Unknown Bacteria (Click photo to enlarge. See more)
1. Plate of sterile MacConkey's; 2. Plate of TSY (front) and MAC (back): What can you conclude about the bacteria growing on MAC?; 3 & 4. MacConkey's plates each streaked with different unknowns; 5. MacConkeys: Different type of bacteria streaked on each of the two plates.
MacConkey's Streaked with Unknown Bacteria (Click photo to enlarge. See more)
1. Sterile pate of Blood Agar; 2 - 5. Blood Agar plates streaked with different clinical samples from human throat. What type of hemolysis pattern is shown in each? Which of these Blood Agar plates indicated pathogenic bacteria?
Blood Agar Streaked with Unknown Bacteria (Click on photo to enlarge.)
SCIENCE PHOTOS
Page last updated: 5/2014
Need help remembering what the media plates looked like when they were sterile, before bacteria began to grow? 1. TSY being inoculated; 2. Blood agar (BAP); 3. Mannitol Salt agar (MSA); MacConkey's agar (MAC);
5. Clockwise from top left: MAC, MSA BAP (bottom).
Sterile Media Photos (Click on photo to enlarge)
Didn't find what you need?
Search SPO for a Photo
Video Tutorials on Specialized Bacterial Growth Media
MacConkey's Agar (MAC) Specialized
Bacterial Growth Medium
Blood Agar (BAP) Specialized
Bacterial Growth Medium
Mannitol Salt Agar (MSA) Specialized
Bacterial Growth Medium
MacConkey's Agar Quiz and Review: How to Interpret MAC
SPO VIRTUAL CLASSROOMS
 | ||||||
 | ||||||
SPO is a FREE science education website. Donations are key in helping us provide this resource with fewer ads.
Please help!
(This donation link uses PayPal on a secure connection.)
SCIENCE VIDEOS
Just click on an image below to enlarge it. Select the "See more" link to view additional photos on that topic. To save an image to your computer, right click on it and select "Save".
For those in need of high-resolution images, we will soon be offering hi-res files of many photos in the Science Image Library. Follow us on Twitter @ScienceProfSPO to get updates on new SPO features and products.
Science Prof Online has a continuously growing collection of free science images. If you use one of our images, we just ask that you give us credit and provide a link to the SPO website (www.scienceprofonline.com).
 | ||||
You have free access to a large collection of materials used in a college-level introductory microbiology course. The Virtual Microbiology Classroom provides a wide range of free educational resources including PowerPoint Lectures, Study Guides, Review Questions and Practice Test Questions.
More Bacterial Growth Media & Cultures Resources
- Comparison of Liquid & Solid Bacterial Growth Media "class notes"article from Science Prof Online.
- Aseptic Technique to Pour Bacterial Growth Media Into Petri Dishes "class notes"article.
- Differential & Selective Bacterial Growth Media "class notes" article.
- Types of Culture Media for Growing Bacteria "class notes" article.
These are three plates of MacConkey's agar. Each plate has a different organism growing on it. What does the media tell you about each of these unknown bacteria?